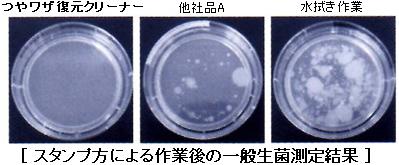

樹脂ケミカル類
光沢復元・保守剤
リンレイ 洗剤 つやワザ復元クリーナー
皮膜再生化技術 「つやワザ」
モップオン(モップ拭き)でも自動床洗浄機でも効果を発揮
新開発、皮膜再生成分(パーティクルエンハンサー)が、皮膜表面を活性化。
滑らかで強い皮膜に再生、汚れも除去。
汚れにくく、長期間の光沢維持が可能です。
◇特長◇
●皮膜再生成分「パーティクルエンハンサー」が傷んだ皮膜表面を修復

●モップオンで、自動床洗浄機で、あらゆる現場の光沢耐久性を強化
新開発「パーティクルエンハンサー」の働きにより、
バフィング作業が行えない様な現場でも長期間の高い美観維持が可能になります。
水拭き、水洗浄の代わりに作業することで光沢耐久性を向上させ、
表面洗浄の周期を延長することが可能です。

●除菌・消臭効果に優れる
洗浄・光沢耐久性強化と同時に除菌。
衛生面を問われる現場や病院などにも適しています。
●バフィングによる光沢復元力に優れる

◇用途◇
樹脂ワックスが塗布された床材の日常管理
◇標準使用量◇
●モップオン
100倍 100㎡/L(通常時)
50倍 60㎡/L(効果優先時)
●自動床洗浄機
300倍 100㎡/L(通常時)
100倍 100㎡/L(効果優先時)
製品情報
| 容量 | 18L |
| 標準使用量 | |
| 粘度 | 約5(mPa・s、@25℃) |
| pH | 7.7(@25℃) |
| 成分 | 水 グリコール系溶剤 アルコール系溶剤 非イオン系界面活性剤 陰イオン系界面活性剤 除菌剤 香料 染料 |












































